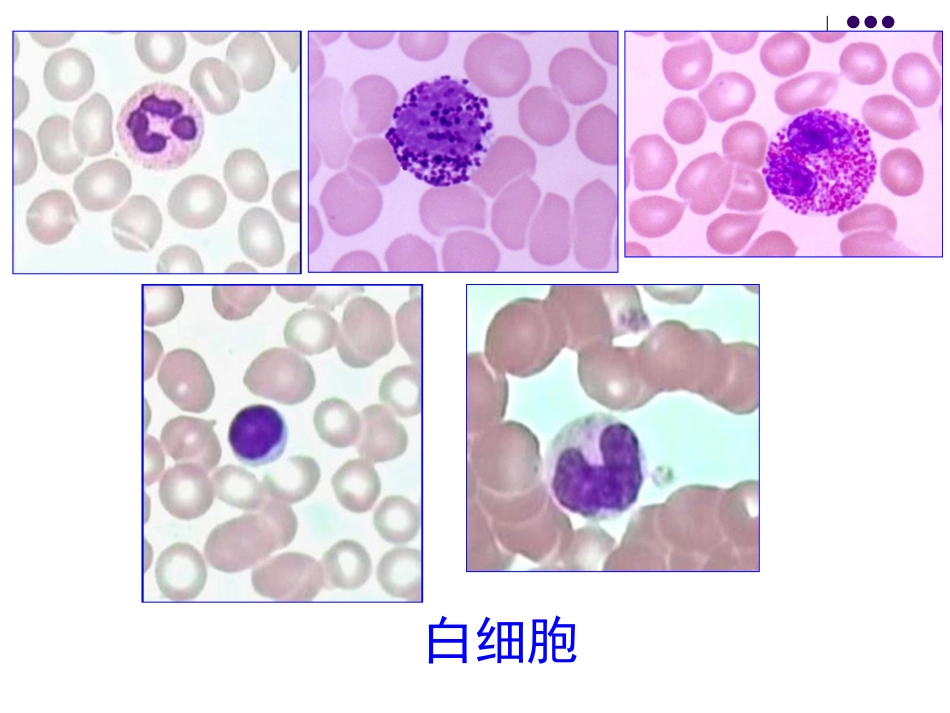
软骨和骨2、肌组织_第2页
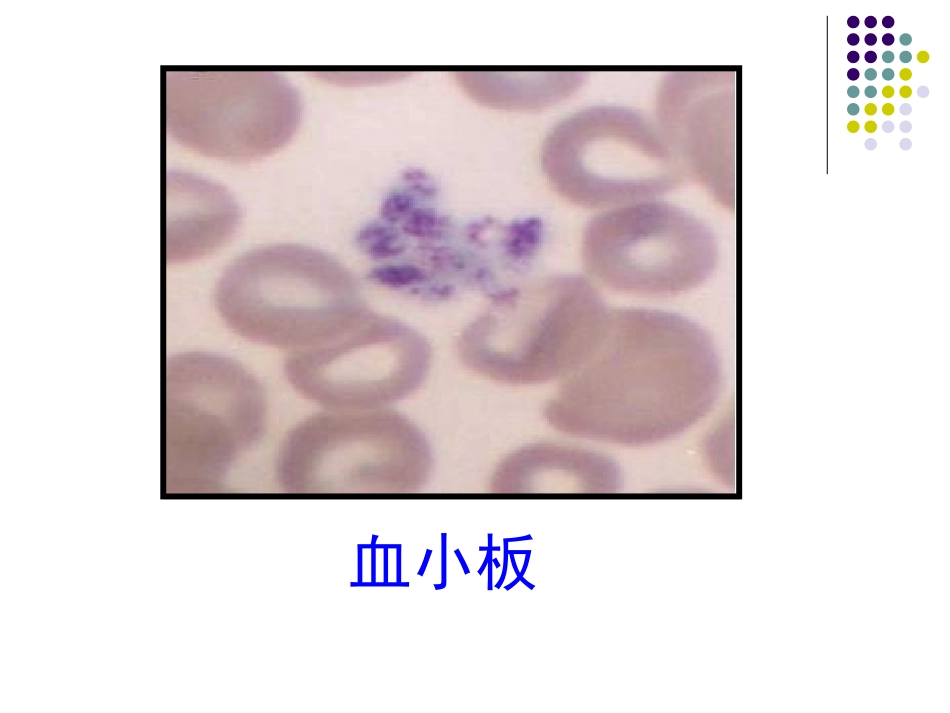
软骨和骨2、肌组织_第3页

复习红细胞白细胞血小板软骨细胞LM:位于软骨陷窝分布规律同源细胞群弱嗜碱性EM:RER、GC功能:产生软骨基质透明软骨弹性软骨纤维软骨胶原原纤维弹性纤维胶原纤维束纤维成分软骨的分类骨组织的细胞骨祖细胞成骨细胞骨细胞破骨细胞第4周授课内容第5章软骨和骨(二)第6章肌组织第5章软骨和骨(二)掌握长骨骨干的结构。名词:哈弗斯系统(骨单位)软骨和骨(二)授课重点二、骨骨组织骨基质细胞骨祖细胞成骨细胞骨细胞破骨细胞骨膜骨髓骨基质(骨质)类骨质钙化骨质大量胶原纤维无定形基质(骨盐):羟基磷灰石结晶有机成分无机成分成分骨质结构骨板:似多层木质胶合板密质骨:骨板层数多,排列规则,结合紧密松质骨:层数少,不规则,片状针状的骨小梁(二)长骨的结构1、骨干22、骨骺、骨骺33、骨膜、骨膜1、骨干:主要由密质骨构成。(1)环骨板外环骨板内环骨板(2)骨单位(3)间骨板(1)环骨板外环骨板:厚,整齐排列内环骨板:薄,排列不规则(2)骨单位位置:内外环骨板之间形状:长筒状结构:由多层同心圆排列的哈弗斯骨板围绕中央管构成;功能:长骨中起支持作用的主要结构。骨单位穿通管滋养孔中央管、穿通管(3)间骨板位置:骨单位之间骨单位与环骨板之间形态:不规则的平行骨板粘合线:位置:环骨板、骨单位、间骨板三者之间骨单位表面特点:骨盐多,胶原纤维少折光性强骨磨片骨磨片间骨板(红)间骨板(红)粘合线(蓝)粘合线(蓝)(1)环骨板外环骨板内环骨板(2)骨单位(3)间骨板骨干2、骨骺:主要由松质骨构成。截骨增高术、拉骨手术3、骨膜骨(外)膜:外层:致密CT(穿通纤维)内层:疏松CT(血管、神经、骨祖细胞)骨内膜:骨祖细胞,CT功能:营养骨组织,为骨的生长和修复提供干细胞第6章肌组织肌组织授课重点掌握骨骼肌、心肌纤维的光、电镜结构。掌握平滑肌纤维的光镜结构特点。名词:肌节闰盘概述:•组成:肌细胞(肌纤维)细胞膜:肌膜细胞质:肌浆细胞核•分类:骨骼肌:心肌:平滑肌:横纹肌不随意肌横纹肌随意肌不随意肌细胞外基质一、骨骼肌概述:肌外膜肌束膜肌内膜(一)骨骼肌纤维的光镜结构•胞体:•胞核:•胞质:长圆柱状,一般无分支多个,扁椭圆形,位于肌膜下方肌原纤维周期性横纹:明带+暗带①暗带(A带),中央有H带,H带中央有M线②明带(I带),中央为Z线A带I带I带Z线Z线M线肌节相邻两条Z线之间的一段肌原纤维;½I带+A带+½I带;骨骼肌纤维结构和功能的基本单位Z线Z线I带A带I带IIAZZ肌节横切面纵切面(二)骨骼肌纤维的超微结构1.肌原纤维2.横小管3.肌浆网1.肌原纤维粗肌丝、细肌丝1.肌丝的分子构成粗肌丝:肌球蛋白细肌丝:肌动蛋白原肌球蛋白肌钙蛋白(1)粗肌丝的分子结构头部:形成横桥,肌球蛋白有ATP酶活性杆部(2)细肌丝的分子结构肌动蛋白、原肌球蛋白、肌钙蛋白为球状的肌动蛋白单体构成的双螺旋链单体上有与肌球蛋白结合的位点肌动蛋白:双股螺旋多肽链,埋于肌动蛋白链的浅沟内。原肌球蛋白:三个球形亚单位组成。TnTTnITnC附着于原肌球蛋白分子上,可与Ca2+结合。肌钙蛋白:细肌丝:肌动蛋白原肌球蛋白肌钙蛋白肌原纤维粗肌丝:肌球蛋白细肌丝:肌动蛋白原肌球蛋白肌钙蛋白2、横小管•形成:•位置:A带与I带交界处•功能:传导兴奋3.肌浆网终池纵小管三联体调节肌浆内Ca2+(钙泵、钙通道)功能:(三)骨骼肌纤维的收缩原理肌丝滑动肌丝滑动原理1.神经冲动肌膜2.横小管终池钙通道开放,Ca2+释放入肌浆3.肌钙蛋白原肌球蛋白肌动蛋白位点暴露4.肌球蛋白头部ATP酶激活肌球蛋白头部屈曲肌动蛋白拉向M线5.细肌丝滑入A带I带H带缩窄,肌节收缩6.收缩完毕,Ca2+泵回肌浆网肌钙蛋白等复位,肌纤维松弛二、心肌(一)心肌纤维的光镜结构•短圆柱状,有分支•1-2个核,卵圆形,居中•周期性横纹•闰盘闰盘:位置:心肌纤维连接处LM:着色深,呈横线或阶梯状EM:横位部分有中间连接和桥粒纵位部分有缝隙连接功能:传导冲动、交流信息心肌纤维及闰盘光镜像(心肌纤维及闰盘光镜像(HemalumHemalum染色)染色)心肌纤维闰盘超微结构示意图心肌纤维闰盘超微结构示意图横切面纵切面(二)心肌纤维的超微结...